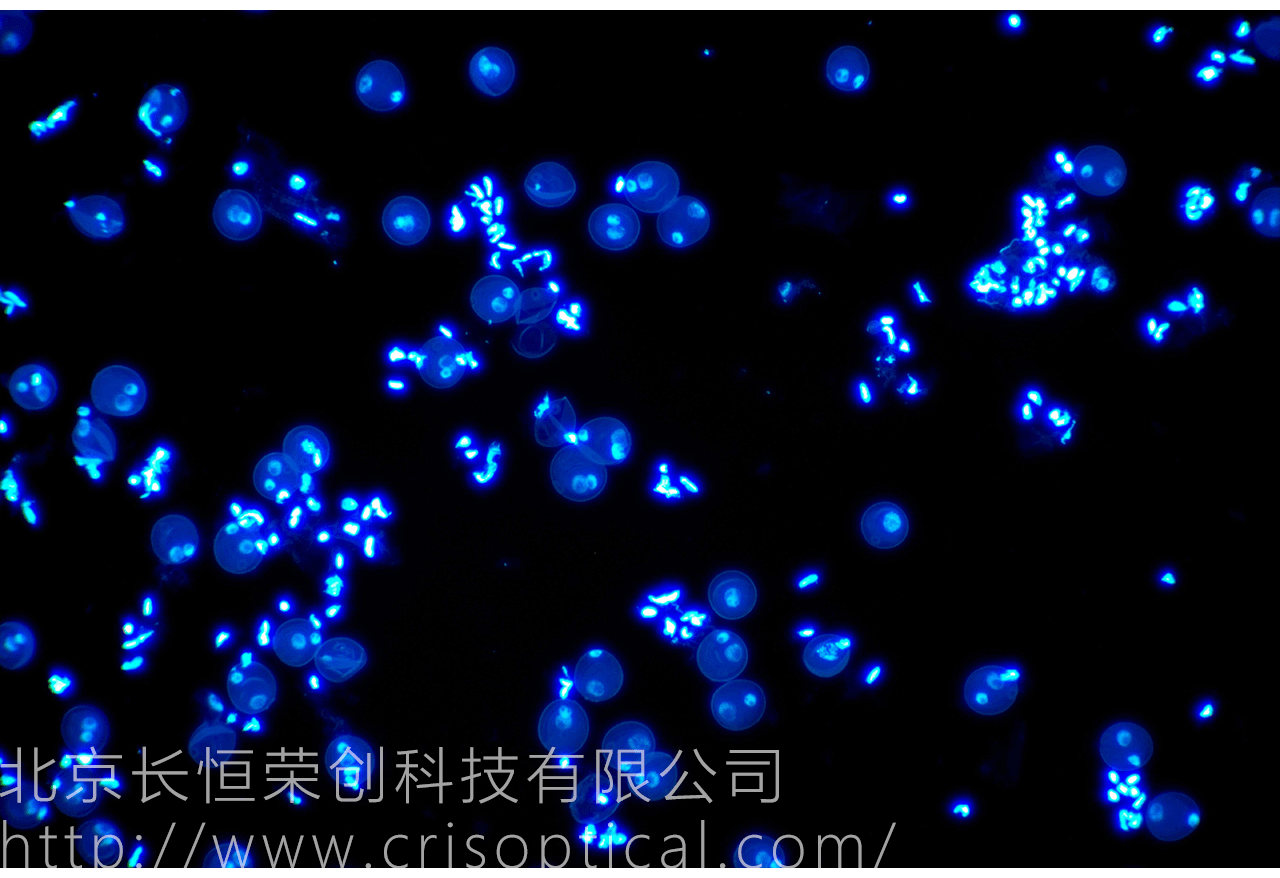

一、實驗用途
植物細胞研究在科學領域中扮演著至關重要的角色,為我們深入了解植物生命的本質提供了基礎。這一領域的研究涵蓋了植物細胞的結構、功能、代謝過程以及細胞與環(huán)境的互動,其應用廣泛而深刻,不僅為農業(yè)生產提供技術支持,也在生物學、醫(yī)學、環(huán)境科學等多個領域取得了豐碩的成果。
農業(yè)生產與遺傳改良: 植物細胞研究在農業(yè)領域中具有巨大的應用潛力。科學家通過對植物細胞的基因組學研究,可以揭示植物的遺傳信息,理解植物的生長發(fā)育規(guī)律,為作物的遺傳改良提供理論基礎。通過基因編輯技術,可以精準地調控植物的性狀,提高抗病性、耐逆性和產量。
植物生理學研究: 植物細胞研究對植物生理學的深入了解至關重要。通過觀察和分析植物細胞的結構和功能,研究者可以揭示植物的生理過程,包括光合作用、呼吸作用、水分運輸?shù)?。這有助于理解植物的生存機制和生長發(fā)育規(guī)律,為合理的農業(yè)管理提供科學依據(jù)。
藥物研發(fā)與醫(yī)學應用: 植物細胞中含有豐富的次生代謝產物,其中一些具有藥用價值。通過植物細胞培養(yǎng)技術,可以在體外大規(guī)模生產植物次生代謝產物,為藥物研發(fā)提供原料。此外,一些植物細胞中的活性物質也被用于醫(yī)學應用,如植物細胞的抗氧化物質在抗衰老研究中發(fā)揮作用。
環(huán)境監(jiān)測與生態(tài)學研究: 植物細胞研究有助于環(huán)境監(jiān)測和生態(tài)學研究。通過植物細胞的生理響應,可以評估環(huán)境中的污染程度,監(jiān)測大氣中的有害氣體,例如二氧化硫、臭氧等。此外,研究植物的適應性和生態(tài)位,有助于了解植物在自然生態(tài)系統(tǒng)中的作用。
食品工業(yè)與植物資源利用: 植物細胞研究在食品工業(yè)中有著廣泛的應用。通過培養(yǎng)植物細胞,可以獲得具有特定性狀的植物組織,例如改良的果實或更多的營養(yǎng)成分。植物細胞還被用于培養(yǎng)人工肉類,為解決全球食品安全和可持續(xù)發(fā)展提供了新的途徑。
教育與科普: 植物細胞研究為教育和科普提供了豐富的內容。通過植物細胞的觀察和實驗,可以生動地展示細胞結構、細胞分裂、染色體行為等基本生物學概念,培養(yǎng)學生對生命科學的興趣和理解。
新材料開發(fā): 植物細胞中的纖維素等物質被廣泛用于生產紙張、纖維等材料。植物細胞壁的結構研究為開發(fā)新型的生物材料提供了啟示,推動了可持續(xù)和環(huán)保的新材料的研發(fā)。
二、案例圖片
注意:以下案例圖片經過壓縮,原圖更加清晰。如需查看原圖效果,請電話或微信聯(lián)系。

三、儀器配置
